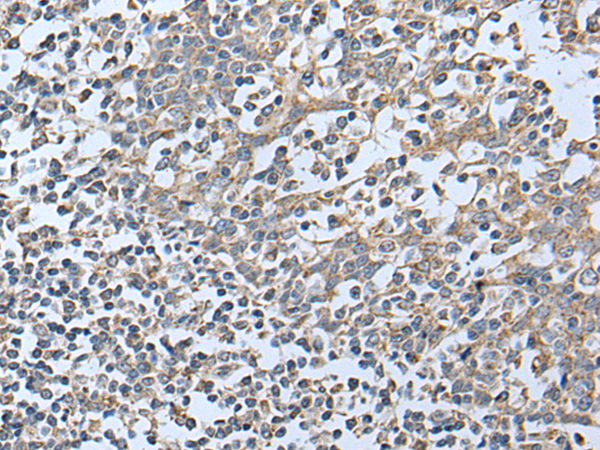
一抗

|
Background: |
Janus kinase 1 (JAK1), is a member of a new class of protein-tyrosine kinases (PTK) characterized by the presence of a second phosphotransferase-related domain immediately N-terminal to the PTK domain. The second phosphotransferase domain bears all the hallmarks of a protein kinase, although its structure differs significantly from that of the PTK and threonine/serine kinase family members. JAK1 is a large, widely expressed membrane-associated phosphoprotein. JAK1 is involved in the interferon-alpha/beta and -gamma signal transduction pathways. The reciprocal interdependence between JAK1 and TYK2 activities in the interferon-alpha pathway, and between JAK1 and JAK2 in the interferon-gamma pathway, may reflect a requirement for these kinases in the correct assembly of interferon receptor complexes. These kinases couple cytokine ligand binding to tyrosine phosphorylation of various known signaling proteins and of a unique family of transcription factors termed the signal transducers and activators of transcription, or STATs. |
|
Applications: |
ELISA, IHC |
|
Name of antibody: |
JAK1 |
|
Immunogen: |
Synthetic peptide of human JAK1 |
|
Full name: |
Janus kinase 1 |
|
Synonyms: |
JTK3; JAK1A; JAK1B |
|
SwissProt: |
P23458 |
|
ELISA Recommended dilution: |
500-1000 |
|
IHC positive control: |
Human tonsil |
|
IHC Recommend dilution: |
25-100 |

 購物車
購物車 幫助
幫助
 021-54845833/15800441009
021-54845833/15800441009